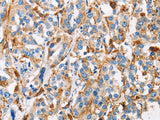
Cathepsin L Polyclonal Antibody Store at -20°C

Cathepsin L Polyclonal Antibody Store at -20°C
SKU: E-AB-10211-200
Cathepsin L Polyclonal Antibody Store at -20°C
| SKU # | E-AB-1021 |
| Reactivity | Human |
| Host | Rabbit |
| Applications | IHC |
Product Details
| Isotype | IgG |
| Host | Rabbit |
| Reactivity | Human |
| Applications | IHC |
| Clonality | Polyclonal |
| Immunogen | Recombinant protein of human CTSL |
| Abbre | CTSL |
| Synonyms | 1 b, CATL, CATL1, CTSL, CTSL1, Cathepsin L1, Cathepsin L1 light chain, CathepsinL, FLJ31037, MEP, MGC123162, Major excreted protein, cathepsin L, cb15, ctsl1b, hgg1, wu:fb30g09 |
| Swissprot | |
| Cellular Localization | Lysosome. |
| Concentration | 0.5 mg/mL |
| Buffer | Phosphate buffered solution, pH 7.4, containing 0.05% stabilizer and 50% glycerol. |
| Purification Method | Affinity purification |
| Research Areas | Cancer, Neuroscience, Signal Transduction |
| Conjugation | Unconjugated |
| Storage | Store at -20°C Valid for 12 months. Avoid freeze / thaw cycles. |
| Shipping | The product is shipped with ice pack,upon receipt,store it immediately at the temperature recommended. |
Related Reagents
| Applications | Recommended Dilution |
| IHC | 1:50-1:200 |
Background
The protein encoded by this gene is a lysosomal cysteine proteinase that plays a major role in intracellular protein catabolism. Its substrates include collagen and elastin, as well as alpha-1 protease inhibitor, a major controlling element of neutrophil elastase activity. The encoded protein has been implicated in several pathologic processes, including myofibril necrosis in myopathies and in myocardial ischemia, and in the renal tubular response to proteinuria. This protein, which is a member of the peptidase C1 family, is a dimer composed of disulfide-linked heavy and light chains, both produced from a single protein precursor. Multiple alternatively spliced transcript variants have been found for this gene.